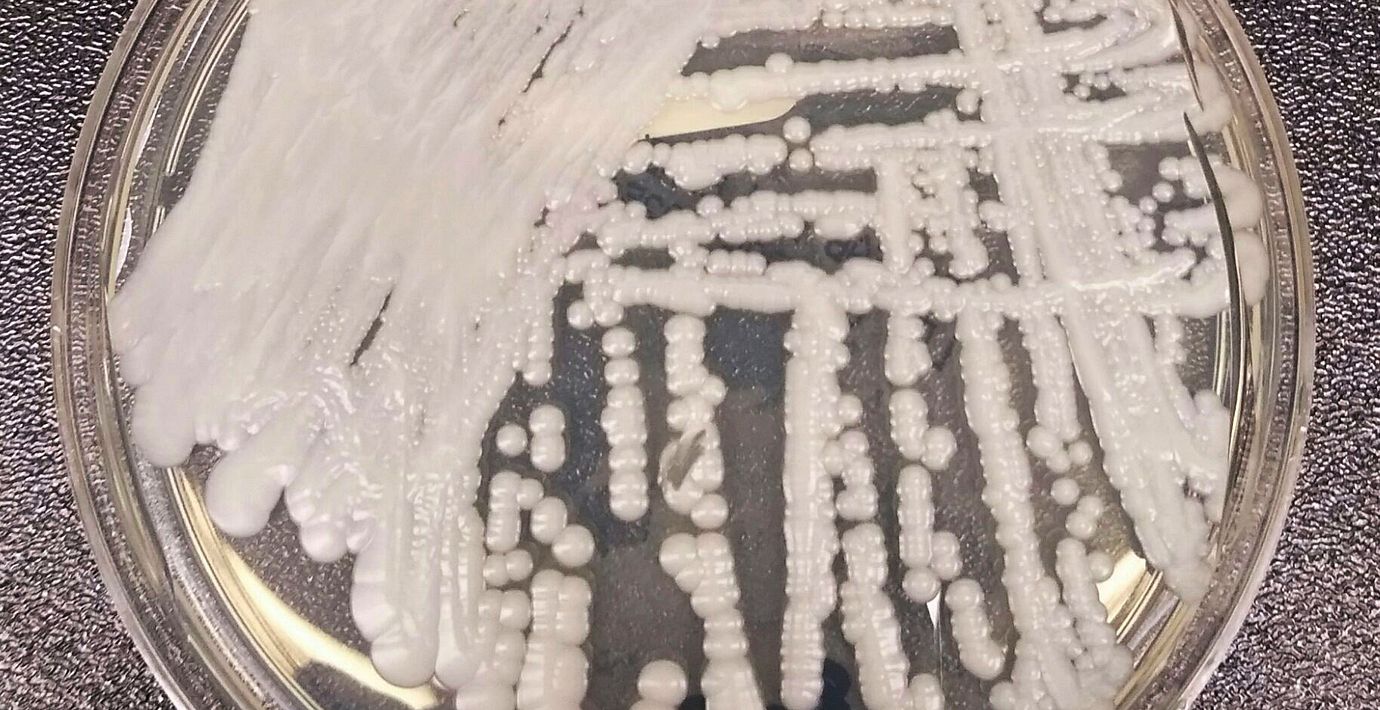

Svenska vården rustar mot multiresistent svamp
Minst tolv regioner har infört screening mot den multiresistenta och smittsamma jästsvampen Candida auris, visar en enkät som Läkartidningen genomfört. Sedan i somras rekommenderar Folkhälsomyndigheten just detta.
Lena Klingspor, docent i klinisk mykologi på Karolinska institutet, tycker att det är viktigt och nödvändigt att regionerna följer rekommendationen.
– Hittills har man inte hittat några medel att behandla de här infektionerna med. De är ofta multiresistenta. Den här jästsvampen är väldigt smittsam och kan överleva på till exempel en bordsyta i flera veckor, säger hon.
Jästsvampen har skapat smittutbrott på sjukhus över hela världen. I Sverige har sex fall rapporterats sedan 2020, enligt Folkhälsomyndigheten. I samtliga fall har patienten smittats på sjukhus utomlands.



